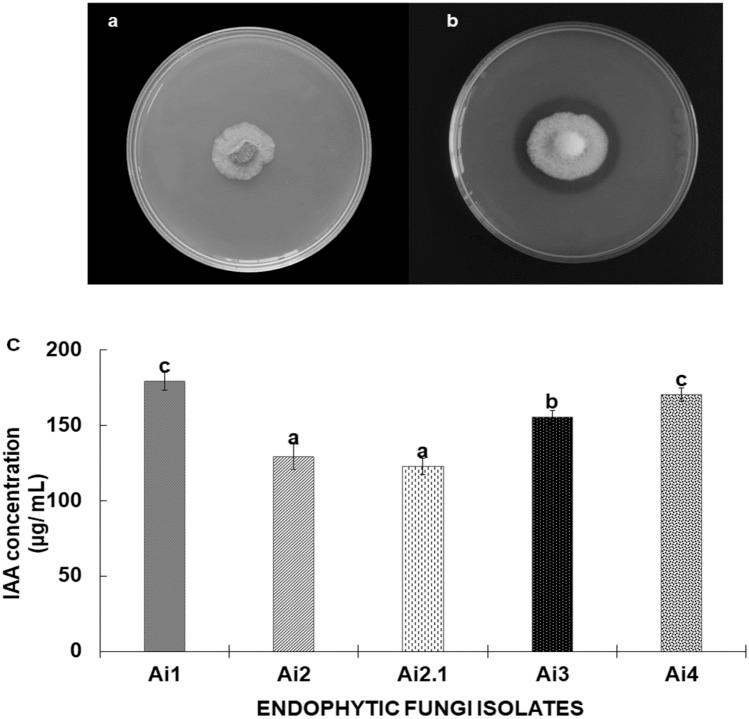
https://cdn.ncbi.nlm.nih.gov/pmc/blobs/a23e/10770348/0a591c0da302/41598_2023_51057_Fig3_HTML.jpg

从药用植物糙苏属植物中生物勘探内生真菌,以发挥其在农业和工业领域的多种作用。
Bioprospecting of endophytic fungi from medicinal plant Anisomeles indica L. for their diverse role in agricultural and industrial sectors.
机构信息
Microbiology Laboratory, Department of Botany, University of North Bengal, Rajarammohunpur, Dist. Darjeeling, West Bengal, 734013, India.
Plant-Fungus Interactions Laboratory, Department of Botany, University of Delhi, Delhi, 110007, India.
出版信息
Sci Rep. 2024 Jan 5;14(1):588. doi: 10.1038/s41598-023-51057-5.
Endophytes are microorganisms that inhabit various plant parts and cause no damage to the host plants. During the last few years, a number of novel endophytic fungi have been isolated and identified from medicinal plants and were found to be utilized as bio-stimulants and bio fertilizers. In lieu of this, the present study aims to isolate and identify endophytic fungi associated with the leaves of Anisomeles indica L. an important medicinal plant of the Terai-Duars region of West Bengal. A total of ten endophytic fungi were isolated from the leaves of A. indica and five were identified using ITS1/ITS4 sequencing based on their ability for plant growth promotion, secondary metabolite production, and extracellular enzyme production. Endophytic fungal isolates were identified as Colletotrichum yulongense Ai1, Colletotrichum cobbittiense Ai2, Colletotrichum alienum Ai2.1, Colletotrichum cobbittiense Ai3, and Fusarium equiseti. Five isolates tested positive for their plant growth promotion potential, while isolates Ai4. Ai1, Ai2, and Ai2.1 showed significant production of secondary metabolites viz. alkaloids, phenolics, flavonoids, saponins, etc. Isolate Ai2 showed maximum total phenolic concentration (25.98 mg g), while isolate Ai4 showed maximum total flavonoid concentration (20.10 mg g). Significant results were observed for the production of extracellular enzymes such as cellulases, amylases, laccases, lipases, etc. The isolates significantly influenced the seed germination percentage of tomato seedlings and augmented their growth and development under in vitro assay. The present work comprehensively tested these isolates and ascertained their huge application for the commercial utilization of these isolates both in the agricultural and industrial sectors.
内生菌是栖息在各种植物部位且不对宿主植物造成损害的微生物。在过去的几年中,已经从药用植物中分离和鉴定了许多新型内生真菌,并发现它们可用作生物刺激素和生物肥料。有鉴于此,本研究旨在从西孟加拉邦 Terai-Duars 地区的重要药用植物 Anisomeles indica L. 的叶片中分离和鉴定内生真菌。从 A. indica 的叶片中总共分离出 10 株内生真菌,其中 5 株根据其促进植物生长、产生次生代谢物和产生细胞外酶的能力,通过 ITS1/ITS4 测序进行鉴定。内生真菌分离物被鉴定为 Colletotrichum yulongense Ai1、Colletotrichum cobbittiense Ai2、Colletotrichum alienum Ai2.1、Colletotrichum cobbittiense Ai3 和 Fusarium equiseti。五种分离物对其具有促进植物生长的潜力进行了测试,而分离物 Ai4、Ai1、Ai2 和 Ai2.1 表现出显著的次生代谢产物生产,如生物碱、酚类、类黄酮、皂苷等。分离物 Ai2 表现出最大的总酚浓度(25.98 mg g),而分离物 Ai4 表现出最大的总黄酮浓度(20.10 mg g)。在细胞外酶如纤维素酶、淀粉酶、漆酶、脂肪酶等的生产方面也观察到了显著的结果。这些分离物显著影响了番茄幼苗的种子发芽率,并在体外试验中促进了它们的生长和发育。本工作全面测试了这些分离物,并确定了它们在农业和工业领域的商业利用中的巨大应用潜力。